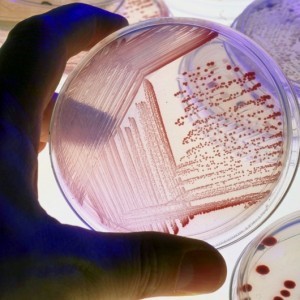
Klebsiella pneumonia (клебсиелла) в моче Klebsiella pneumonia (клебсиелла) в моче

Клебсиелла пневмония — бактерия, вызывающая инфекции, в том числе мочевых путей. Эта статья рассматривает заболевания, связанные с этим микроорганизмом, их симптомы, диагностику и лечение. Понимание роли Клебсиеллы пневмония в инфекциях мочевых путей важно для медицинских специалистов и пациентов, так как это способствует своевременному выявлению и эффективному лечению заболеваний, предотвращая осложнения.
Что такое klebsiella pneumoniae?
Возбудителем данной инфекции является бактерия klebsiella pneumoniae. Основное отличие клебсиеллы от других грамотрицательных бактерий заключается в наличии защитной капсулы, которая служит барьером. Эта оболочка защищает микроорганизм от неблагоприятных условий внешней среды и механических повреждений, что затрудняет его обнаружение в организме. Защищённая капсула делает бактерию устойчивой к антибиотикам, что приводит к длительному и сложному процессу лечения.
Патогенные микроорганизмы, вызывающие заболевание, могут быть выявлены только при отсутствии симптомов, с помощью анализа мазка из горла и кала.
Факторы, способствующие развитию заболеваний:
- ослабление иммунной системы;
- игнорирование правил личной гигиены;
- предрасположенность к простудам;
- длительный прием антибиотиков;
- высокий уровень сахара в крови;
- наличие наркотической или алкогольной зависимости.
В некоторых случаях симптомы заболевания проявляются так ярко, что организм истощается из-за выделения токсинов.
Клебсиелла пневмония поражает дыхательную систему. При отсутствии лечения воспалительные процессы в лёгких могут значительно увеличиваться, затрагивая целые доли. Это приводит к гибели лёгочных клеток, образованию абсцессов, а также к появлению каверн и эмпием плевры. Быстрое развитие болезни объясняется особенностями возбудителя klebsiella pneumoniae, в частности, его способностью разрушать ткани. Многие пациенты сталкиваются с различными плевральными выпотами.
Пневмония может проявляться метастатическими воспалительными очагами в костях, оболочках мозга, мочевом пузыре и тонком кишечнике. В некоторых случаях хроническое течение болезни может привести к летальному исходу.
Клебсиелла, как и другие бактерии, способна к размножению, что сопровождается выделением большого количества токсинов, вызывающих воспалительные процессы. Пневмония, вызванная этой бактерией, чаще всего наблюдается у пожилых людей, чья иммунная система уже не в состоянии справляться с заболеванием. Хронические бронхолегочные осложнения часто сопутствуют пневмонии.
Наличие клебсиеллы в моче указывает на возможную инвазию.
Врачи отмечают, что Клебсиелла пневмония является одной из наиболее частых причин инфекций мочевых путей. Эта бактерия может вызывать различные заболевания, такие как цистит, пиелонефрит и уретрит. Специалисты подчеркивают, что инфекции, вызванные Клебсиеллой, часто встречаются у пациентов с ослабленным иммунитетом, а также у тех, кто перенёс хирургические операции или длительное лечение антибиотиками.
Медики акцентируют внимание на том, что своевременная диагностика и адекватное лечение являются ключевыми факторами в борьбе с этими инфекциями. Врачи рекомендуют проводить регулярные обследования, особенно для групп риска, чтобы предотвратить развитие осложнений. Важно также учитывать, что устойчивость Клебсиеллы к антибиотикам становится всё более распространенной, что усложняет лечение. Поэтому специалисты призывают к внимательности и осторожности в отношении симптомов, чтобы избежать серьёзных последствий для здоровья.
Клебсиелла пневмония является одной из наиболее распространенных бактерий, вызывающих инфекции мочевых путей. Эксперты отмечают, что данная бактерия может приводить к различным заболеваниям, включая цистит, пиелонефрит и уретрит. Инфекции, вызванные Клебсиеллой, часто наблюдаются у пациентов с ослабленным иммунитетом, а также у людей, проходящих катетеризацию. Важно отметить, что Клебсиелла пневмония обладает способностью развивать устойчивость к антибиотикам, что усложняет лечение. По мнению специалистов, ранняя диагностика и адекватная терапия являются ключевыми факторами в борьбе с инфекциями, вызванными этой бактерией. Профилактика, включая соблюдение гигиенических норм и контроль за состоянием здоровья, также играет важную роль в снижении риска возникновения заболеваний, связанных с Клебсиеллой.

Симптоматика заболевания
Инфекция проявляется остро. Наблюдаются:
- резкие приступы слабости;
- сильная головная боль;
- лихорадка и озноб;
- покраснение в горле;
- кратковременные приступы боли в боку, возникающие при глубоком вдохе;
- проявление цианоза.
Прямой показатель пневмонии — нарастающий сухой кашель, сопровождающийся отделением вязкой мокроты с включением кровяных сгустков.
Клебсиеллезное воспаление дыхательных путей характеризуется такими особенностями:
- тяжёлым течением болезни;
- внезапным началом;
- резкими плевральными болями;
- отделением мокроты с кровяными сгустками;
- неприятным запахом мокроты;
- выраженной интоксикацией организма.
| Заболевание | Симптомы | Диагностика и лечение |
|---|---|---|
| Цистит | Частое и болезненное мочеиспускание, жжение при мочеиспускании, мутная моча, кровь в моче, боль внизу живота. | Общий анализ мочи, посев мочи на флору и чувствительность к антибиотикам. Лечение: антибиотики (например, ципрофлоксацин, нитрофурантоин), обильное питье. |
| Пиелонефрит | Высокая температура, озноб, боль в пояснице (односторонняя или двусторонняя), тошнота, рвота, общая слабость. | Общий анализ мочи, посев мочи, УЗИ почек, анализ крови (общий, биохимический). Лечение: антибиотики (внутривенно или перорально), жаропонижающие, дезинтоксикационная терапия. |
| Уретрит | Боль и жжение при мочеиспускании, выделения из уретры (гнойные или слизистые), зуд в уретре. | Мазок из уретры на микрофлору, ПЦР-диагностика. Лечение: антибиотики (например, доксициклин, азитромицин), местные антисептики. |
| Простатит (у мужчин) | Боль в промежности, мошонке, паху, затрудненное и болезненное мочеиспускание, частые позывы к мочеиспусканию, лихорадка. | Пальцевое ректальное исследование, анализ секрета простаты, УЗИ предстательной железы. Лечение: антибиотики, противовоспалительные препараты, физиотерапия. |
| Бактериемия/Сепсис (при распространении инфекции) | Высокая температура, озноб, тахикардия, одышка, спутанность сознания, падение артериального давления. | Посев крови на стерильность, общий анализ крови, биохимический анализ крови, определение маркеров воспаления. Лечение: интенсивная антибактериальная терапия (внутривенно), поддержание жизненно важных функций. |
Интересные факты
Клебсиелла пневмония — это бактерия, которая может вызывать различные заболевания, включая инфекции мочевых путей. Вот несколько интересных фактов о ней:
-
Устойчивость к антибиотикам: Клебсиелла пневмония известна своей способностью развивать устойчивость к множеству антибиотиков, что делает лечение инфекций, вызванных этой бактерией, особенно сложным. Некоторые штаммы обладают механизмами, позволяющими им выживать даже при воздействии карбапенемов, что является серьезной проблемой для здравоохранения.
-
Симптомы и осложнения: Инфекции мочевых путей, вызванные Клебсиеллой, могут проявляться различными симптомами, включая болезненное мочеиспускание, частые позывы к мочеиспусканию и боль внизу живота. В тяжелых случаях инфекция может привести к пиелонефриту (воспалению почек) и даже к сепсису, что требует немедленного медицинского вмешательства.
-
Риск для определенных групп населения: Клебсиелла пневмония чаще всего поражает людей с ослабленным иммунитетом, таких как пациенты с диабетом, пожилые люди или те, кто перенес хирургические операции. Также она может быть связана с использованием катетеров и других медицинских устройств, что увеличивает риск инфекций в больничной среде.

Особенности диагностики
При проведении общего осмотра врач может обнаружить слабые хрипы в легких, которые, к слову, могут сопровождаться появлением мелких кровоизлияний на коже и слизистых оболочках внутренних органов.
В ходе общего анализа крови фиксируется снижение количества лейкоцитов, что приводит к состоянию анемии.
Рентгенологическое исследование позволяет более детально изучить картину заболевания. На рентгеновских снимках можно увидеть участки затемнения в легких, иногда достигающие значительных размеров. Характерной чертой воспалительных процессов являются плевритические проявления и полости распада в органах.
Пневмония, вызванная клебсиеллой, затрагивает дыхательную систему не только взрослых, но и детей, включая новорожденных. Изменения в стуле и выраженные колики у младенца должны вызывать беспокойство. При появлении таких симптомов рекомендуется незамедлительно обратиться к квалифицированному педиатру.
Клебсиелла пневмония — это бактерия, способная вызывать различные инфекции, в том числе и в мочевыводящих путях. Многие пациенты сообщают о неприятных симптомах, связанных с инфекцией: частые позывы к мочеиспусканию, жжение и боль при этом, а также общее недомогание. Врачи подчеркивают, что Клебсиелла представляет особую опасность для людей с ослабленным иммунитетом или хроническими заболеваниями. Важно отметить, что лечение таких инфекций требует комплексного подхода, включая применение антибиотиков, однако устойчивость бактерий к медикаментам становится все более распространенной проблемой. Поэтому профилактика, такая как соблюдение гигиенических норм и своевременное обращение к врачу, играет ключевую роль в предотвращении инфекций, вызванных этой бактерией.
Методологическое выявление возбудителя
Исследование состава биологической среды под микроскопом направлено на обнаружение очага возбуждения инфекции. По итогам диагносту удаётся выделить бактерии, определить чувствительность организма к антибиотикам.
Попавшие в организм бактерии провоцируют возникновение воспалительных процессов внутренних органов, которые влекут за собой развитие серьёзных осложнений под видом сепсиса.
Встречаются случаи выделения клибсиеллы в моче во время беременности. Это вызывает серьёзные опасения как у женщин, так и у медиков. В норме моча абсолютно стерильная жидкость и никаких бактерий в ней не должно присутствовать. В случаях выявления клебсиеллы у беременной женщины, анализ рекомендовано пересдать, чтобы исключить возможность попадания в ёмкость влагалищных бактерий. В норме у здоровой женщины бактерий клебсиеллы в мазке из половых органов и анализе кала присутствовать не должно.

Как определить, что в моче бактерии
Анализы на наличие клебсиеллы в моче проводятся при подозрении на инфекционные заболевания. Появление определённых симптомов может указывать на это. К основным симптомам относятся:
- болезненные ощущения при мочеиспускании;
- тупые, ноющие боли в нижней части живота. У женщин они могут ощущаться над мочевым пузырём, у мужчин — в области прямой кишки;
- ощущение неполного опорожнения мочевого пузыря.
Если в моче обнаруживается бактерия klebsiella pneumonia, это свидетельствует о её способности вызывать пневмонию и сопутствующие осложнения. Обычно данные бактерии развиваются в следующих условиях:
- на кожных покровах;
- в гортани;
- в желудочно-кишечном тракте;
- в дыхательных путях;
- в незаживших ранах после операций, где уже могут образовываться абсцессы.
Инфекции мочевых путей, вызванные клебсиеллой, чаще всего встречаются у детей, пожилых людей и лиц с ослабленным иммунитетом. Ранняя и точная диагностика заболеваний мочевых путей позволяет начать лечение без задержек. В случаях, когда инфекция ещё не достигла критического состояния, её можно успешно устранить. Важно правильно выбрать препараты для терапии и определить оптимальную схему лечения, так как бактерии чувствительны к антибиотикам узкого спектра действия.
Клинические методы терапии
Иногда проблема решается сама собой — организму удаётся побороть инфекцию самостоятельно, в случае, если количество бактерий в моче (без проявления симптомов заболевания) умеренное, а возбудитель несёт неагрессивный характер. Но такой вариант решения проблемы категорически неприемлем:
- для беременных женщин;
- для людей преклонного возраста;
- для людей с ослабленным иммунитетом.
Присутствие инфекции в период беременности может негативно повлиять на плод. Поэтому наличие клебсиеллы в моче беременных — серьёзная проблема, угрожающая здоровью малыша.
Особое внимание обращают на пациентов:
- переживших операцию по пересадке почки;
- страдающих от рефлюкса мочеиспускательных путей;
- с наличием камней в мочевике или почках.
Бактериемия сопровождается такими явлениями:
- присутствие болезненых ощущений во время мочеиспускания;
- частые позывы к мочеиспусканию;
- болезненность процесса мочеиспускания;
- давящие ощущения в области мочевого пузыря;
- присутствие в мочи кровяных выделений.
Обнаружив хотя бы один из выше прописанных симптомов бактериемии klebsiella pneumoniae, посетите уролога.
Противобактериальные методы лечения осуществляются по специальным нормам, которые поддаются постоянному мониторингу специалистами. Мониторинг средств терапии позволяет следить за реакциями бактерий на лекарства. Так, адаптировавшись к флоре, создаваемой антибиотиками, бактерии продолжают свою жизнедеятельность, а такой препарат уже бездействен в борьбе с инфекцией. Поэтому противомикробные средства необходимо постоянно изменять, только так их эффективность возможно сохранить. Учитывая особенности бактерий, схема лечения и методы терапии подбираются индивидуально для каждого пациента.
Бактерия клебсиеллы опасна для жизни человека. Поэтому заподозрив симптомы инвазии, обязательно обратитесь за помощью к врачам. Лечить пневмонию, вызванную бактериями, необходимо только стационарно и только медицинскими средствами. Помните обо всей серьёзности болезни и возможных последствиях, берегите своё здоровье!
Иван Георгьевич Сафонов
Профилактика инфекций, вызванных Klebsiella pneumoniae
Профилактика инфекций, вызванных Klebsiella pneumoniae, является важной задачей как для медицинских учреждений, так и для пациентов. Эта бактерия, обладая высокой устойчивостью к антибиотикам и способностью вызывать различные инфекции, требует особого внимания к мерам предосторожности и профилактическим стратегиям.
Одним из ключевых аспектов профилактики является соблюдение строгих стандартов гигиены. Это включает в себя регулярное мытье рук с мылом, особенно в медицинских учреждениях, где риск передачи инфекции значительно выше. Использование антисептиков на спиртовой основе также может помочь снизить вероятность передачи Klebsiella pneumoniae.
Вторым важным направлением является контроль за использованием антибиотиков. Избыточное и неправильное применение антибиотиков может привести к развитию устойчивости бактерий, что делает лечение инфекций более сложным. Врачи должны следовать рекомендациям по назначению антибиотиков и избегать их назначения при вирусных инфекциях, где они неэффективны.
Также важным аспектом профилактики является вакцинация. Хотя на данный момент не существует вакцины, специально разработанной против Klebsiella pneumoniae, вакцинация против других инфекций, таких как грипп и пневмококковая инфекция, может снизить риск развития осложнений и вторичных инфекций, связанных с этой бактерией.
Для пациентов с ослабленным иммунитетом или хроническими заболеваниями, такими как диабет или заболевания почек, особенно важно следить за состоянием здоровья и обращаться за медицинской помощью при первых признаках инфекции. Регулярные медицинские осмотры и мониторинг состояния здоровья могут помочь в раннем выявлении и лечении инфекций.
Наконец, важным аспектом является обучение медицинского персонала и пациентов. Понимание путей передачи Klebsiella pneumoniae, симптомов инфекций и методов профилактики может значительно снизить риск заражения. Образовательные программы и информационные кампании могут повысить осведомленность о данной проблеме и способствовать более эффективной профилактике инфекций.
Вопрос-ответ
Какие заболевания вызывает клебсиелла пневмония?
Может вызывать различные инфекции, включая пневмонию, сепсис, инфекции мочевыводящих путей, бактериемию, менингит и абсцессы в печени.
Что такое клебсиелла пневмония в моче?
Клебсиелла пневмонии представляет собой бактерию, которая также может вызывать инфекции мочевыводящих путей, особенно у людей с ослабленной иммунной системой или с другими медицинскими состояниями.
Что вызывает инфекцию мочевыводящих путей, вызванную клебсиеллой?
Попадание бактерий Klebsiella pneumoniae в мочевыводящие пути может вызвать инфекцию. Вероятность этого выше, если во время пребывания в больнице вам поставили катетер. Инфекции мочевыводящих путей, вызванные Klebsiella pneumoniae, могут представлять угрозу для жизни, особенно у людей с серьёзными заболеваниями.
Какой антибиотик убивает клебсиеллу в моче?
Лечение инфекций, вызванных Klebsiella, Enterobacter и Serratia. Цефалоспорины, цефепим, карбапенемы, фторхинолоны, пиперациллин/тазобактам или аминогликозиды.
Советы
СОВЕТ №1
Регулярно проходите медицинские обследования, особенно если у вас есть предрасположенность к инфекциям мочевых путей. Это поможет выявить проблемы на ранней стадии и предотвратить развитие более серьезных заболеваний.
СОВЕТ №2
Обратите внимание на гигиену. Соблюдение правил личной гигиены, особенно после посещения туалета и половых актов, может значительно снизить риск заражения клебсиеллой и другими бактериями.
СОВЕТ №3
Увлажняйте организм, употребляя достаточное количество воды. Это поможет поддерживать нормальное функционирование мочевых путей и способствует выведению бактерий из организма.
СОВЕТ №4
При появлении симптомов инфекции мочевых путей, таких как болезненное мочеиспускание или частые позывы, не откладывайте визит к врачу. Раннее лечение может предотвратить осложнения и улучшить прогноз.